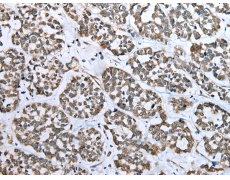
一抗

中文名稱:兔抗CARTPT多克隆抗體
英文名稱: Anti-CARTPT rabbit polyclonal antibody
別 名: CART
相關(guān)類別: 一抗
儲 存: 冷凍(-20℃)
宿 主: Rabbit
抗 原: CARTPT
反應(yīng)種屬: Human, Mouse, Rat
標(biāo) 記 物: Unconjugate
克隆類型: rabbit polyclonal
技術(shù)規(guī)格
|
Background: |
This gene encodes a secreted protein which is processed by prohormone/proprotein convertases to produce smaller, biologically active peptides. Expression of the transcript for this gene is regulated by certain drugs such as cocaine, and the encoded protein is thought to be involved in the regulation of appetite and stress. Mutations in this gene are associated with susceptibility to obesity. |
|
Applications: |
ELISA, WB, IHC |
|
Name of antibody: |
CARTPT |
|
Immunogen: |
Full length fusion protein |
|
Full name: |
CART prepropeptide |
|
Synonyms: |
CART |
|
SwissProt: |
Q16568 |
|
ELISA Recommended dilution: |
5000-10000 |
|
IHC positive control: |
Human esophagus cancer |
|
IHC Recommend dilution: |
25-100 |
|
WB Predicted band size: |
13 kDa |
|
WB Positive control: |
Rat heart tissue and Mouse brain tissue |
|
WB Recommended dilution: |
500-2000 |


 購物車
購物車 幫助
幫助
 021-54845833/15800441009
021-54845833/15800441009